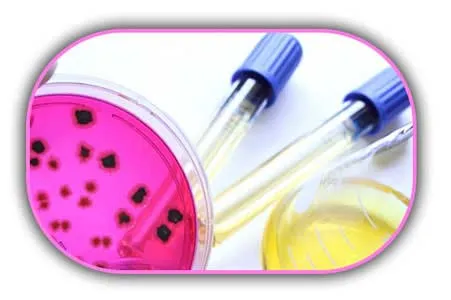
Aerobik-Koloni-Sayımı

Mikrobiyolojik Analizler
Gıda Maddeleri doğal olarak çok sayıda mikroorganizma içermektedir. Bu sayı belli bir sınırı aştığında ise gıdalar tüketilemez duruma gelmektedir. Bu da sağlık açısından risk oluşturmaktadır. Laboratuvarımızda yapılan mikrobiyolojik analizleri aşağıda sizler için listeledik.
-
Aerobik Koloni Sayımı
-
E.coli Sayımı
-
Bacillus Cereus Sayımı
-
Koliform Bakteri Sayımı
-
Enterobacteriaceae Sayımı
-
Koagülaz Pozitif Sitafilakokların Sayımı
-
Küf ve Maya Sayımı
-
Salmonella Spp Aranması
-
Listeria Monocytogenes Aranması
-
Escherichia Coli 0157:H7 Aranması
-
Sülfit İndirgeyen Anaerobik Bakteri Sayımı
-
E.coli, Koliform Bakteri Sayımı
-
Enterococcus & Streptococcus Aranması
-
22C ve 37C ‘de Üreyebilen Mikroorganizmaların Sayımı
-
Stafilokokal Enterotoksin Aranması
Aerobik Koloni Sayımı
Mezofilik aerobik bakteri analizi ya da bir diğer adıyla aerobik koloni sayısı oldukça yaygın bir şekilde kullanılan kalite standartlarından biri olarak kabul edilmektedir. Bazı kolileri sayılması ile elde edilen toplam bakteri sayısı gıdaların kalitesi ile ilgili önemli bir veriye dönüşüyor. Mikroorganizmaların kültürde çoğaltılması ve oluşan kolonilerin sayılması prensibine dayanmaktadır. Tüm gıda maddeleri hasattan tüketiciye ulaşana kadar geçen tüm aşamalarda mikroorganizmalarla kontamine olurlar. Gıdalarda bulunan mikroorganizma yükü, limitleri aşarsa halk sağlığı tehlikeye girmektedir. Bu sebeple gıdalarda mikroorganizma yükü özellikle gıda güvenliği açısından kontrol edilmesi gereken önemli bir parametredir.
Aslında toplam bakteri diye standart bir kültürel analiz yoktur. Toplam bakterilerin sayılması için çok özel cihazlara ve analizlere gerek duyulmaktadır. Standart olarak yapılan analizlerde psikrofil, mezofil ve termofil gruplarında ve aerobik/anaerobik koşullarda elde edilen bakteri sayıları belirlenmektedir.
Bunlar arasında en fazla, toplam aerobik mezofilik bakteri sayısının belirlenmesi için analizler yapılmaktadır. Toplam aerobik mezofilik bakteri sayımı, gıdalar için çok yaygın yapılan, kolay ve ucuz bir kalite standardıdır. Aerobik bakteri sayımı gibi analizler ile tüketilen gıdaların kalitesi hakkında fikir sahibi olabilmekteyiz. Toplam aerobik mikroorganizma sayımı, kalite parametrelerinden biri olarak kabul edilmektedir. Toplam aerobik mikroorganizma sayımı ile gıdanın üretim, depolama ve taşıma gibi aşamalarının koşulları, katkı maddelerinin kullanımı ve raf ömrü hakkında bilgi sahibi olunabilir. Toplam mezofilik aerobik bakteri sayımı için, bir katı besiyerinde belli bir sıcaklıkta belli bir süre ile ve uygun koşullarda gelişen koloniler sayılmakta ve gıda maddelerindeki toplam aerobik mezofilik bakteri sayısı tespit edilmektedir.
Bunlar arasında en fazla, toplam aerobik mezofilik bakteri sayısının belirlenmesi için analizler yapılmaktadır. Toplam aerobik mezofilik bakteri sayımı, gıdalar için çok yaygın yapılan, kolay ve ucuz bir kalite standardıdır. Aerobik bakteri sayımı gibi analizler ile tüketilen gıdaların kalitesi hakkında fikir sahibi olabilmekteyiz. Toplam aerobik mikroorganizma sayımı, kalite parametrelerinden biri olarak kabul edilmektedir. Toplam aerobik mikroorganizma sayımı ile gıdanın üretim, depolama ve taşıma gibi aşamalarının koşulları, katkı maddelerinin kullanımı ve raf ömrü hakkında bilgi sahibi olunabilir. Toplam mezofilik aerobik bakteri sayımı için, bir katı besiyerinde belli bir sıcaklıkta belli bir süre ile ve uygun koşullarda gelişen koloniler sayılmakta ve gıda maddelerindeki toplam aerobik mezofilik bakteri sayısı tespit edilmektedir.
Özellikle uzun süre ve soğuk ortamda bekletilen gıda maddeleri için psikrofil aerobik bakteri sayımı önemlidir. Gıda ürünlerinin ne zaman bozulmaya başladığı ya da raf ömrünün net bir şekilde belirlenmesi gibi çalışmalar için bu analiz çalışmasına ihtiyaç duyulmaktadır. Çünkü gıda ürünlerinin bozulmaya başladı dönemin son tüketim tarihi olarak ambalaj üzerine de eklenmesi gerektiği için önem arz etmektedir.
Aerobik bakteri sayımlarında genel olarak; psikrofilik, mezofilik, termofilik gruplarında ve aerobik / anaerobik koşullardaki bakteri sayıları belirlenir. En yaygın olarak yapılan mikrobiyolojik analiz de ‘Toplam Mezofilik Aerobik Koloni Sayımı’ dır. Aerobik bakteri sayımı gibi analizler ile tüketilen gıdaların kalitesi hakkında fikir sahibi olabiliriz. Bu nedenle, üretilen gıdanın tüketime kadar geçtiği tüm aşamalar hakkında bilgi sahibi olabilmek için aerobik koloni sayımı gibi analiz işlemleri yapılmaktadır.
Toplam aerobik mikroorganizma sayımı, kalite parametrelerinden biri olarak kabul edilmektedir. Toplam aerobik mikroorganizma sayımı ile gıdanın üretim, depolama ve taşıma gibi aşamalarının koşulları, katkı maddelerinin kullanımı ve raf ömrü hakkında bilgi sahibi olunabilir. Gıdalarda “Aerobik Koloni Sayımı (Aerobik Bakteri Sayımı)” için bize ulaşabilirsiniz.
Sonuç olarak gıdaların raf ömrünün belirlenmesi için basit bir analiz çalışmasının yeterli olduğunu belirtebiliriz. Özellikle çiğ sütlerin mikrobiyolojik kalitesinin belirlenmesinde bu bakteri sayımının kullanıldığını belirtelim. Ürün hammaddelerinden ya da üretimi tamamlanan gıdalardan belirli bir miktarda numune olarak bize ulaştırmanız gerekli çalışmanın hızlıca yapılması için yeterli olmaktadır. Numuneyi tarafımıza ne şekilde ulaştırmanız gerektiği konusunda daha detaylı bilgi almak için ya da sorularınızı yöneltmek için bizi arayabilirsiniz.
Toplam bakteri (jerm) sayımı -genel olarak- hijyen kontrolü amacıyla yapılır. Toplam bakteri ile “toplam mezofil aerob bakteri” kastedilir. Toplam psikrofiller, toplam termofiller ve diğer gruplarda da (Anaerob) sayım aynı esas ile yapılır. Kimi kaynaklarda APS (Anaerobik Plate Count) ve AKS (Aerobik Koloni Sayısı) olarak ifade edilen budur. Analiz edilen örnekte PCA besiyerinde gelişebilen mayalar varsa bunlar da sayıma dâhil edilir. Küfler genel olarak 24 ila 48 saat inkübasyonda gelişerek koloni oluşturamazlar. Çoğu kez Plate Count Agar olmak üzere, genel bir besiyerinde standart yayma ya da dökme yöntemiyle ekim ve inkübasyondan sonra bu besiyerinde oluşan koloniler sayılarak bakteri sayısı belirlenir. Plate Count Agar besiyeri, ISO 4833 ve FDA Form 2400a 3/01 ve daha pek çok uluslararası standarda uygun olarak toplam bakteri analizinde kullanılmaktadır. Bu bakteri sayımı çalışması ile gıda maddelerinde ya da yardımcı olarak üretimde kullanılan maddelerde ambalaj işlemi aşamasından sonra bakteri olup olmadığının belirlenmesi de mümkün olabiliyor.
Ambalajlama aşaması ya da sonrasında depolama aşaması gibi üretim sonrası aşamalarda gıda maddelerinde ne oranda bakteri ürettiği sorusunun yanıtı için söz konusu analiz çalışmasından siz de faydalanabilirsiniz.
E.coli Sayımı
 Compact Dry EC, E.coli ve koliform grubu bakterilerin tanımlanabilmesi için kullanıma hazır halde bulunan kromojenik hazır besiyeri dir. İçeriğinde koliforma kırmızı renk ve E.coli ’ye mavi renk veren 2 çeşit kromojenik enzim substratı (Magenta-GAL ve X-GLUC) bulunmaktadır. Kromojenik substratlar / redox indikatörleri sayesinde mikroorganizmalar spesifik renklerde gelişim gösterir ve koloni sayımı çok net bir şekilde yapılmaktadır. Standardizasyonu sağlayarak personel hatasını minimuma indirir. Üretimin her aşamasında ve ortam analizlerinde kullanıma uygundur
Compact Dry EC, E.coli ve koliform grubu bakterilerin tanımlanabilmesi için kullanıma hazır halde bulunan kromojenik hazır besiyeri dir. İçeriğinde koliforma kırmızı renk ve E.coli ’ye mavi renk veren 2 çeşit kromojenik enzim substratı (Magenta-GAL ve X-GLUC) bulunmaktadır. Kromojenik substratlar / redox indikatörleri sayesinde mikroorganizmalar spesifik renklerde gelişim gösterir ve koloni sayımı çok net bir şekilde yapılmaktadır. Standardizasyonu sağlayarak personel hatasını minimuma indirir. Üretimin her aşamasında ve ortam analizlerinde kullanıma uygundur
Compact Dry Besiyeri aşağıdaki özelliklere sahiptir:
- Uzun raf ömrüne sahiptir (12-18 ay), oda sıcaklığında saklanır. Buzdolabı gerektirmez.
- Türk Gıda Kodeksi içerisinde yer alan analiz metotları ile eşdeğerlilik gösterir.
- Numune inokülasyon aşamasında kendiliğinden homojen bir şekilde difüze olarak yayılır, herhangi bir aparata ihtiyaç duyulmaz.
- Kilitli kapaklıdır, %100 sterildir.
Klasik analiz yöntemindeki çalışma güvenilirliğini sağlar. İnkübatör ( Bir inkübatör, mikrobiyolojik kültürleri veya hücre kültürlerini büyütmek ve sürdürmek için kullanılan bir cihazdır. İnkübatör, optimum sıcaklık, nem ve içindeki atmosferin CO₂ ve oksijen içeriği gibi diğer koşulları korur.) içerisine istiflenebilir. Zemindeki katı kartuş küçük gözeneklerden oluştuğu için her koloni ayrı ayrı gözlemlenebilir, kolonileri saymak için ayrı bir cihaza ihtiyaç yoktur. Petri kabı mantığı olduğundan mikroorganizmalar 3 boyutlu büyüme gösterir. Compact Dry Besiyerleri analiz sonrası 6-12 ay arasında şahit numune olarak arşivlenebilmektedir. Her ürünün üzerinde, son kullanma tarihi mevcuttur ayrıca üzerinde yer alan lot numarasına (kimlik numarasına) ait analiz sertifikaları ürün ile birlikte kullanıcıya gönderilir.
Önemli Notlar: E.coli O157:H7 formları mavi koloniler arasındadır. Üreyen mavi renkteki kolonilerin %10’u O157:H7 formu olarak kabul edilir. Sonuç olarak mavi okunan E.coli’ler sıfıra indirildiğinde O157:H7 formlarının üründe olmadığı kabul edilir. Gıdalarda, hastalık yapan ve asla bulunmaması gereken mikroorganizmalardan biri de Koliform bakterilerdir. Koliform bakterilerin en bilineni ve zararlı olan Escherchia Coli’ dir. E.coli, çoğunlukla memeli hayvanların bağırsaklarında yaşamaktadır. Bu nedenle gıdalara bulaşmış olması demek ürünün dışkı ile bir şekilde kontamine olması demektir.
E.coli, en tehlikeli patojen mikroorganizmalardandır. Vücut ısısında hızlı bir şekilde çoğalır ve ölümcül rahatsızlıklara neden olur. E.coli önemli bir hijyen kriteri kabul edilir. Bir gıda işletmesinde yüzey, personel ve kullanım sularında kontrol edilir. Gıdalarda “Escherchia coli Aranması” için bize ulaşabilirsiniz.
Bacillus Cereus Sayımı
 Bacillus cereus; aerobik, çubuk şeklinde, spor oluşturan, gram pozitif, toprak ve bitki yüzeyinde yaygın olarak bulunan bir bakteridir. Bacillus cereus, oluşturdukları toksinlerden kaynaklı iki farklı zehirlenmeye neden olmaktadır. Aerobik spor oluşturan bir bakteri türüdür. Toprak kökenli olduğundan dolayı tarla ve bahçe ürünlerinde daha sıklıkla rastlanabileceği gibi et ve süt ürünlerinde de görülebilir. Bacillus cereus, yaygın olarak süt, pirinç, diğer tahıllar, baharat, et ve tavuk gibi ürünlerde zehirlenmelere yol açabilir. Op-mum üreme sıcaklığı, suşlara göre 28-35°C arasında eğişmekle birlikte genelde 30°C dir.
Bacillus cereus; aerobik, çubuk şeklinde, spor oluşturan, gram pozitif, toprak ve bitki yüzeyinde yaygın olarak bulunan bir bakteridir. Bacillus cereus, oluşturdukları toksinlerden kaynaklı iki farklı zehirlenmeye neden olmaktadır. Aerobik spor oluşturan bir bakteri türüdür. Toprak kökenli olduğundan dolayı tarla ve bahçe ürünlerinde daha sıklıkla rastlanabileceği gibi et ve süt ürünlerinde de görülebilir. Bacillus cereus, yaygın olarak süt, pirinç, diğer tahıllar, baharat, et ve tavuk gibi ürünlerde zehirlenmelere yol açabilir. Op-mum üreme sıcaklığı, suşlara göre 28-35°C arasında eğişmekle birlikte genelde 30°C dir.
Oda sıcaklığında kolaylıkla gelişir ve sporları kolaylıkla çimlenir. Gelişebildiği pH aralığı 4,9-9,3 olup op-mum 7,0’dır. Polimiksine dirençlidir.
İşlenmiş ve çiğ gıdalarda >106/g olduğunda, zehirlenmeye neden olabilmektedir. Özellikle Bacillus cereus ile kontamine olmuş gıdalar, pişirildikten sonra, yeterince hızlı soğutulmadıklarında veya gıdaların hazırlanması ile tüketimi arasındaki süre uzadığında, canlı ve ısıya dirençli sporların çimlenmesi sonucu organizma çoğalıp gıda zehirlenmesine neden olabilecek düzeyde toksin oluşturabilir.
Riskli Gıdalara Örnek Olarak: Bacillus cereus, aerob, endospor oluşturan, gram pozitif, hareketli bir bakteridir. Genellikle diyarel ve emetik olmak üzere iki tip gıda kaynaklı hastalık tablosu oluşturmaktadır. Riskli gıdalar arasında et, süt, pirinç, pudingler, pastalar, sebzeler, balıklar, makarnalar ve peynir yer almaktadır. Standart analiz yöntemi besiyerinde koloni saymaktadır. Amaca göre EMS yöntemi ile sayım ya da var/yok testleri de yapılabilmektedir. Bacillus Cereus; aerobik, çubuk şeklinde, spor oluşturan, gram pozitif, toprak ve bitki yüzeyinde yaygın olarak bulunan bir bakteridir. Bacillus Cereus, oluşturdukları toksinlerden kaynaklı iki farklı zehirlenmeye neden olmaktadır. Bacillus Cereus, aerobik spor oluşturan bir bakteri türüdür. Toprak kökenli olduğundan dolayı tarla ve bahçe ürünlerinde daha sıklıkla rastlanabileceği gibi et ve süt ürünlerinde de görülebilir. B. cereus, yaygın olarak süt, pirinç, diğer tahıllar, baharat, et ve tavuk gibi ürünlerde zehirlenmelere yol açabilir. Gıdalarda “Bacillus Cereus Sayımı” için bize ulaşabilirsiniz.
Koliform Bakteri Sayımı
 Koliform bakteriler gıda ve suların sıhhi durumunu gösteren göstergeç bakterilerdir. Tanım olarak çubuksu, Gram-negatif olup 35-37 °C’de laktoz fermante ederek asit ve gaz üretirler. Koliformlar sıcak kanlı hayvanların ( Vücut ısısı ortama göre değişmeyen hayvanlara sıcak kanlı hayvanlar denir. Memeliler ve kuşlar sıcak kanlı hayvanlara örnek olarak verilebilmektedir) dışkılarında bolca bulunurlar, ama sulak ortamlarda, toprakta ve bitkilerde de bulunurlar.
Koliform bakteriler gıda ve suların sıhhi durumunu gösteren göstergeç bakterilerdir. Tanım olarak çubuksu, Gram-negatif olup 35-37 °C’de laktoz fermante ederek asit ve gaz üretirler. Koliformlar sıcak kanlı hayvanların ( Vücut ısısı ortama göre değişmeyen hayvanlara sıcak kanlı hayvanlar denir. Memeliler ve kuşlar sıcak kanlı hayvanlara örnek olarak verilebilmektedir) dışkılarında bolca bulunurlar, ama sulak ortamlarda, toprakta ve bitkilerde de bulunurlar.
Koliform Bakteri Sayımı Testi ; Bu yönteme göre; her biri 20 ml LB besiyeri içeren 15 adet tüpe, 5 X 10 ml, 5 X 1 ml ve 5 X 0,1 ml olacak şekilde ekim yapılmakta ve tüpler 35 oC ‘de 24-48 saat inkübasyona bırakılmaktadır. İnkübasyon sonunda gaz oluşturan tüpler muhtemel koliform olarak kabul edilmektedir. Bakteri bulaşması Yöntemleri; Bu bakterinin kirlilik kaynakları lağım suyu bulaşmış bitkiler, mikroplu tanklar, hayvan dışkısı gibi geniş bir yelpazedir. Evcil hayvanlar da bu kirliliğe katkıda bulunmaktadır.
Çoğu koliform bakterisi doğal su kaynaklarına, insan ve hayvan dışkısı veya atık suların karışması şeklinde doğrudan bulaşır. Bu bakterinin kirlilik kaynakları lağım suyu bulaşmış bitkiler, mikroplu tanklar, hayvan dışkısı gibi geniş bir yelpazedir. Evcil hayvanlar da bu kirliliğe katkıda bulunmaktadır. Çoğu koliform bakterisi doğal su kaynaklarına, insan ve hayvan dışkısı veya atık suların karışması şeklinde doğrudan bulaşır.
Enterobacteriaceae Sayımı
 Enterobacteriaceae, Salmonella ve Escherichia coli gibi ünlü hastalık etkenlerini de içeren büyük bir bakteri ailesidir. Genetik araştırmalar, bu aileyi, Proteobacteria şubesine koyar. Enterobacteriales takımının içinde yer alan tek familyadır. Bilimsel yayınlarla doğrulanmış 32 cinsi mevcuttur.
Enterobacteriaceae, Salmonella ve Escherichia coli gibi ünlü hastalık etkenlerini de içeren büyük bir bakteri ailesidir. Genetik araştırmalar, bu aileyi, Proteobacteria şubesine koyar. Enterobacteriales takımının içinde yer alan tek familyadır. Bilimsel yayınlarla doğrulanmış 32 cinsi mevcuttur.
Gıda sektöründe bulunan gıda üreticilerinin ürünleri arasında bulunan ve oluşabilen bakteri türleri oldukça geniş bir yelpazeye sahiptir. Bakteri üremesi ürün içeriğinde olabileceği gibi aynı zamanda bulundukların ortamlardan da bulaşabilme olasılığı yüksektir. İşleme, depolama ve taşıma aşamalarında yeni bakteriler ile her an karşılaşabilmesi mümkündür. Enterobacteriaceae sayımı, gıda sektöründe önemli bir hijyen kriteridir. Enterobacteriaceae sayımı; gıda üretim alanının, personelin hijyeni hakkında bilgi verir. Bu grupta koliform bakteriler, fekal koliformlar, E.coli (Tip 1), E. coli O157:H7 serotipi, Salmonella, Shigella ve Yersinia enterocolitica bulunmaktadır. Enterobacteriaceae familyası gıda sektörünü en çok etkileyen bakterilerdir.
Bu grupta bulunan bakteriler bir çok laboratuvarda rutin analizlere tabii tutulur aranır veya sayımı yapılır. Bunun yanı sıra Enterobacteriaceae sayımı da günden güne önem kazanıp bir kalite değeri olarak karşımıza çıkmaktadır. Genel olarak hijyen standart olarak kabul edilen bu sayımın uluslararası standartlarda belirli bir limit değeri bulunmamaktadır. Analiz genellikle dökme ya da yayma kültüre sayım yöntemi kullanılarak yapılmaktadır. Enterobacteriaceae familyası içerisinde; toplam koliform bakteriler, fekal koliform bakteriler ve E. Coli yer alır. Sonuç olarak Enterobacteriaceae sayımının sonucu sıfır ise toplam koliform bakteri, fekal koliform bakteri ve E. coli sayısı da sıfır olacaktır. Enterobacteriaceae sayımı, gıda sektöründe önemli bir hijyen kriteridir. Enterobacteriaceae sayımı; gıda üretim alanının, personelin hijyeni hakkında bilgi verir. Bu grupta koliform bakteriler, fekal koliformlar, E.coli (Tip 1), E. coli O157:H7 serotipi, Salmonella, Shigella ve Yersinia enterocolitica bulunmaktadır.
Bu bakteriler gıda mikrobiyolojisi laboratuvarlarında sıklıkla analizlerde aranır veya sayılır. Enterobacteriaceae familyası gıda sektörünü en çok etkileyen bakterilerdir. Bu grupta bulunan bakteriler bir çok laboratuvarda rutin analizlere tabii tutulur aranır veya sayımı yapılır. Bunun yanı sıra Enterobacteriaceae sayımı da günden güne önem kazanıp bir kalite değeri olarak karşımıza çıkmaktadır. Enterobacteriaceae familyası içerisinde; toplam koliform bakteriler, fekal koliform bakteriler ve E. Coli yer alır. Sonuç olarak E.coli sayımının sonucu sıfır ise toplam koliform bakteri, fekal koliform bakteri ve Enterobacteriaceae sayısı da sıfır olacaktır. Bu bakteriler gıda mikrobiyolojisi laboratuvarlarında sıklıkla analizlerde aranır veya sayılır. Gıdalarda “Enterobacteriaceae Sayımı” için bize ulaşabilirsiniz.
Koagülaz Pozitif Sitafilakokların Sayımı
 Gıda mikrobiyolojisinde genellikle Staphylococcus denildiğinde Staphylococcus aureus akla gelmektedir. Stafilokoklar, insan sağlığını tehdit eden patojenlerdir ve genellikle el ve ayak derisinde, ağız-burun derisinde ve mukozasında, saç ve bıyık gibi kıl diplerinde görülür. Özellikle vücut direnci düşük, insanlarda enterotoksin varlığı ciddi problemler oluştururlar. S. aureus başta olmak üzere stafilokoklar, pişmiş ve yüksek protein miktarına sahip gıdalarda enterotoksin üretirler ve gıda zehirlenmelerine neden olurlar. 100 gramında en az 100 ng enterotoksin bulunan gıdanın tüketilmesi ile Stafilokokal Gıda Zehirlenmesi görülebilir. Gıda endüstrisinde çalışan kişilerde genellikle burun veya ellerinde S. aureus bakterisine rastlanabilir. Yani hijyen kurallarına uyulmayan yerlerde karşımıza çıkar.
Gıda mikrobiyolojisinde genellikle Staphylococcus denildiğinde Staphylococcus aureus akla gelmektedir. Stafilokoklar, insan sağlığını tehdit eden patojenlerdir ve genellikle el ve ayak derisinde, ağız-burun derisinde ve mukozasında, saç ve bıyık gibi kıl diplerinde görülür. Özellikle vücut direnci düşük, insanlarda enterotoksin varlığı ciddi problemler oluştururlar. S. aureus başta olmak üzere stafilokoklar, pişmiş ve yüksek protein miktarına sahip gıdalarda enterotoksin üretirler ve gıda zehirlenmelerine neden olurlar. 100 gramında en az 100 ng enterotoksin bulunan gıdanın tüketilmesi ile Stafilokokal Gıda Zehirlenmesi görülebilir. Gıda endüstrisinde çalışan kişilerde genellikle burun veya ellerinde S. aureus bakterisine rastlanabilir. Yani hijyen kurallarına uyulmayan yerlerde karşımıza çıkar.
Gıda ürünlerinde, S. aureus aranmakta ve alınan sonuca göre üretim, işletme hijyeni, personel hijyeni ve çalışma ortamı hakkında fikir sahibi olabilmekteyiz. Bu test, özelilkle stafilokoklarda bulunan ve kan plazmasını pıhtılaştıran koagulase enzimini (stafilokoagulase) ortaya koyma, patojenik olanlarla nonpatojenik olanları ayırmak amacı ile yapılır. Patojenik olan S. aureus pozitif reaksiyon vermesine karşın S. epidermidis ve S. saprophyticus negatif reaksiyon gösterir. Patojen olan stafilokok suşlarında pigment ve hemoliz görülebilir.
Patojenik stafilokok suşlarının ayırımında spesifik besiyeri olarak DNase testi için DNase agardan yararlanılır. Stafilokoklar, insan sağlığını tehdit eden patojenlerdir ve genellikle el ve ayak derisinde, ağız-burun derisinde ve mukozasında, saç ve bıyık gibi kıl diplerinde görülür. Özellikle vücut direnci düşük, insanlarda enterotoksin varlığı ciddi problemler oluştururlar. Staphylococcus aureus başta olmak üzere stafilokoklar, pişmiş ve yüksek protein miktarına sahip gıdalarda enterotoksin üretirler ve gıda zehirlenmelerine neden olurlar. 100 gramında en az 100 ng enterotoksin bulunan gıdanın tüketilmesi ile Stafilokokal Gıda Zehirlenmesi görülebilir.
Gıda ürünlerinde, Staphylococcus aureus aranmakta ve alınan sonuca göre üretim, işletme hijyeni, personel hijyeni ve çalışma ortamı hakkında fikir sahibi olabilmekteyiz. Gıdalarda “Koagülaz Pozitif Stafilokokların Sayımı (Staphylococcus aureus ve diğer türler)” için bize ulaşabilirsiniz.
Küf ve Maya Sayımı
 Bazı maya ve küf türleri gıda sanayiinde faydalı mikroorganizmalar olarak kullanılırlarken, pek çok tür ise fermentasyon ve gıda sanayinde istenmeyen kontaminantlardır ve bu türler genellikle saprofit özellikte olup gıdanın bozulmasına ve üretimin istenilen şekilde sonuçlanmamasına sebep olabilirler. Maya ve küfler, oldukça geniş pH aralığında (pH 2-9), depolama sıcaklığında (10-35 oC) ve su aktivitesinde (0,85 ve üzeri) üreyebilmektedirler. Yüksek tuz ve şeker konsantrasyonuna sahip ortamlarda kolaylıkla gelişebilmekle birlikte, kompleks karbonhidratları, organik asitleri, proteinleri ve lipitleri de kullanabilmektedirler. Bozulmaya yol açan maya ve küfler gıdalarda acı tat ve kötü koku oluşumu, gaz oluşturma özellikleri sayesinde, bazı gıdalarda istenmeyen gözenekli yapı oluşumu gibi bir takım bozukluklara neden olabilmektedirler. Bazı küf türleri ise bulaştıkları gıda maddesinde gelişerek salgıladıkları toksik metabolitler, mikotoksinler nedeniyle, gıda maddesinin tüketilmesi durumunda ölümle sonuçlanabilen zehirlenmelere yol açabilmektedirler. Bazı maya küflerin ise enfeksiyona neden olabilir.
Bazı maya ve küf türleri gıda sanayiinde faydalı mikroorganizmalar olarak kullanılırlarken, pek çok tür ise fermentasyon ve gıda sanayinde istenmeyen kontaminantlardır ve bu türler genellikle saprofit özellikte olup gıdanın bozulmasına ve üretimin istenilen şekilde sonuçlanmamasına sebep olabilirler. Maya ve küfler, oldukça geniş pH aralığında (pH 2-9), depolama sıcaklığında (10-35 oC) ve su aktivitesinde (0,85 ve üzeri) üreyebilmektedirler. Yüksek tuz ve şeker konsantrasyonuna sahip ortamlarda kolaylıkla gelişebilmekle birlikte, kompleks karbonhidratları, organik asitleri, proteinleri ve lipitleri de kullanabilmektedirler. Bozulmaya yol açan maya ve küfler gıdalarda acı tat ve kötü koku oluşumu, gaz oluşturma özellikleri sayesinde, bazı gıdalarda istenmeyen gözenekli yapı oluşumu gibi bir takım bozukluklara neden olabilmektedirler. Bazı küf türleri ise bulaştıkları gıda maddesinde gelişerek salgıladıkları toksik metabolitler, mikotoksinler nedeniyle, gıda maddesinin tüketilmesi durumunda ölümle sonuçlanabilen zehirlenmelere yol açabilmektedirler. Bazı maya küflerin ise enfeksiyona neden olabilir.
Gıdalarda maya ve küf analizi, gıda örneğinde mevcut diğer bakterilerin gelişiminin önlenerek küf ve mayaları izole edip, sayımı ilkesine dayanır. Maya ve küf sayımı için kullanılan besiyerlerinde bakterilerin gelişerek koloni oluşturmaları, yüksek asitlik veya çeşitli antibiyotikler kullanılarak engellenir. Çoğu standartta toplam küf ve maya sayısı dikkate alınırken, maya ve küf sayılarının ayrı ayrı ele alınması da mümkündür. Bu durumda besiyerlerinde bu iki mikroorganizmaların morfolojileri göz önünde bulundurularak ayrı ayrı sayımları yapılır veya amaca uygun olarak farklı özelliklerde besiyerleri kullanılabilir. Örneğin, sadece mayaların gelişmesi isteniyorsa besiyeri bileşimine %0,25 oranında sodyum propiyonat katılarak küf gelişimi baskılanabilir.
Aseptik koşullarda alınarak laboratuara getirilen gıda maddesi 1:10 oranında homojenize edilir ve aynı şekilde ileri seyreltimleri yapılır.(10², 10³,…) Yani 25 g örnek 225 ml diusyon sıvısı içine veya 10 g örnek 90 ml. dilusyon sıvısı içine tartılır ve stomacher de karıştırılır. Dilusyon serileri içinse 1:10 luk seyreltimden başlayarak 10 ml. alınır ve ayrı bir 90 ml. dilusyon sıvısı içine ilave edilir ve vortex blender ’da karıştırılır. Her seyreltimden daha önce hazırlanmış selektif agar plaklarına 0,1 ml yayma plak tekniği ile ekim yapılır. Petriler 25-28 C’ de 3-5 gün süreyle inkübe edilir. 3., 4. ve 5. günlerde incelenir. 5. Gün sonunda tam sayım yapılır ve sonuç kob/ml (gr) olarak kaydedilir.
Küflerin mayalara göre geç koloni oluşturmaları ve kolonilerin, daha önceden oluşmuş maya kolonilerinin üzerini örtme ve sayımını zorlaştırmaları olasılığına karşılık, mayaların daha erken sayılması veya petri üzerinde işaretlenmesi (4-3. Gün) ve 5. Günün sonunda tam sayımın yapılması yararlı bir uygulamadır. Sayımda petri yüzeyindeki uygun sayım aralığındaki (10 – 100) üremeler sayılıp seyreltim faktörü ile çarpılarak küf-maya sayımı ayrı ayrı veya toplam olarak kaydedilir. Küf ve maya analizlerinde dökme plak yöntemi ve yayma plak yöntemi kullanılabilmekle beraber, besiyeri yüzeyinde maya ve küflerin daha hızlı üremesi, düzgün ve standart koloni oluşumu, sayım sonrası izolasyon ve identifikasyon kolaylığı nedeni ile yayma plak yöntemi daha çok tercih edilmektedir. APHA ve IDF yönergelerine uygundur. In vitro (canlı hücre dışında) yapılan standart mikrobiyolojik analizlerde maya ve küflerin geliştirilmesi ve sayılması için selektif katı besiyeri olarak kullanılır. Hazırlanmış besiyeri pembe renklidir ve 25 oC ‘da pH’sı 5,6±0,2’dir. Küfler; “miselyum oluşturan çok hücreli funguslar”, mayalar ise “tek hücreli ve genellikle miselyum oluşturmayan yapılar” olarak tanımlanır. Maya ve küf tayini, gıda üzerindeki bakterilerin gelişimleri önlenir ve maya – küf izole edilerek sayılması esasına dayanır.
Maya ve küfler gıdada, yapı bozukluklarına, gaz oluşumuna, acı tat ve kötü kokuya neden olabildiği gibi salgıladıkları toksik madde nedeniyle gıda zehirlenmelerine de neden olurlar. Maya ve küf özellikle açıkta pazarlanan, paketleme öncesi açık havaya maruz kalan, ambalaj materyalinden bulaşma olabilen, yıkama ve soğutma/dondurma dışında herhangi bir ısıl işlem görmeyen ürünler için bir kalite kriteridir. Gıda ürünlerinde, küf ve maya aranmakta ve alınan sonuca göre üretim, işletme hijyeni, personel hijyeni ve çalışma ortamı hakkında fikir sahibi olabilmekteyiz. Gıdalarda “Maya ve Küf Sayımı” için bize ulaşabilirsiniz.
Salmonella Spp Aranması
 Enterobacteriaceae familyasına ait, Gram negatif, spor oluşturmayan, fakültatif Anaerob, çubuk formunda olup, çoğu (S.Pullorum, S.Gallinarum ve S.Arizonea serotipleri hariç) peritrik flagellaları ile hareketlidir. Tüm Salmonella lar glikozu fermente ederek gaz oluşturur, birkaç tanesi hariç diğerleri laktoz ve sakkarozu parçalayamaz. 6 – 47 0C’ler arasında üreyebilmektedirler. Optimum üreme dereceleri 35 - 37 0C’dir. Soğuğa karşı çok dayanıklıdırlar. Buz içerisinde aylarca canlı kalabilirler. Optimum gelişme pH değeri 6,5-7,5’dir. Ancak pH 4,0-9.0 değerleri arasında da üreyebilmektedir.
Enterobacteriaceae familyasına ait, Gram negatif, spor oluşturmayan, fakültatif Anaerob, çubuk formunda olup, çoğu (S.Pullorum, S.Gallinarum ve S.Arizonea serotipleri hariç) peritrik flagellaları ile hareketlidir. Tüm Salmonella lar glikozu fermente ederek gaz oluşturur, birkaç tanesi hariç diğerleri laktoz ve sakkarozu parçalayamaz. 6 – 47 0C’ler arasında üreyebilmektedirler. Optimum üreme dereceleri 35 - 37 0C’dir. Soğuğa karşı çok dayanıklıdırlar. Buz içerisinde aylarca canlı kalabilirler. Optimum gelişme pH değeri 6,5-7,5’dir. Ancak pH 4,0-9.0 değerleri arasında da üreyebilmektedir.
Gelişebilecekleri su aktivitesi (aw değeri) 0,945-0,999 değerleri arasındadır. % 8’lik tuz konsantrasyonlarında bulunabilmektedir. 550C’de 1 saatte, 600C’de 15-20 dakika inaktive olmaktadır. Karbonhidratlardan gaz ve asit oluştururlar. Yalnız laktoz ve sakkarozu fermente edemezler. Salmonella cinsi içinde yalnız insanlarda, yalnız hayvanlarda ve hem insanlarda hem de hayvanlarda hastalık yapan birçok serotip bulunmaktadır. Salmonella, özellikle et, kümes hayvanları, yumurta ve yumurtalı ürünler gibi bazı hayvansal gıdalardan ve içme sularından insanlara bulaşarak enfeksiyona neden olur. Esas itibariyle fekal orijinlidir. Tüketime hazır gıdalarda Salmonella bulunması o gıda maddesi için risk işaretidir. Bunlardan ilk kez Salmonella choleraesuis 1886 yılında «Salmon» tarafından izole edilmiş, sonraları bu cinse «Salmonella» adı verilmiştir. Salmonella ‘ya genellikle koliform grup bakteriler tarafından yoğun düzeyde kontamine olmuş gıdalarda rastlanır. Klasik bir gıda enfeksiyonu olarak bilinen Salmonellosisin etmeni Salmonella’ların gıda mikrobiyolojisindeki önemleri büyüktür. Salmonella’ların neden olduğu gastroenterit de ölümle sonuçlanabilir.
Mikrobiyal gıda zehirlenmeleri arasında dünyada en çok görülen hastalıklardan biri olan salmonellosisin sadece Amerika Birleşik Devletleri’nde yılda 2-4 milyon kadar vakaya neden olduğu ve hastalık sayısının giderek arttığı tahmin edilmektedir.
Gıda maddelerinde çok düşük düzeyde Salmonella bulunsa bile bunlar riskli olarak kabul edilir. Dolayısıyla gıda maddeleri, içme ve kullanma sularında Salmonella bulunmasına izin verilmez. İthal veya ihraç edilecek ürünlerde Salmonella bulunması, sayısı ve cinsi önemli olmaksızın o gıda maddesinin reddedilmesi için yeterli bir sebeptir. Sıcaklığa dayanıksız bir bakteri olduğundan gıdada Salmonella bulunması ısıl işlem sonrası bir kontaminasyonun veya yetersiz ısıl işlemin bir göstergesidir. Salmonella üyelerinin ürettiği H2S, ortamda bulunan Fe ile reaksiyona girerek Fes oluşturduklarından besiyerinde siyah renkli koloniler meydana getirirler. Besiyerinin içerdiği bizmut iyonları metalik bizmuta indirgendiğinde oluşan kolonilerin etrafı metalik parlaklık kazanmaktadır. Tipik Salmonella kolonileri kahverengi, gri veya siyah, genellikle metalik parlaklık veren koloniler oluşturmaktadır. Bazı suşları besiyerinde kararma ile birlikte yeşil koloniler oluşturabilmektedir
Listeria Monocytogenes Aranması
 Listeria monocytogenes insan ve hayvanlarda değişik enfeksiyonlar meydana getiren, gram pozitif, tekli veya kısa zincir formunda, çomak şeklinde, hareketli (18-26°C’de), sporsuz ve kapsülsüz bir bakteridir. Son derece dayanıklı ve 4°C (buzdolabı sıcaklığı) - 37°C (vücut sıcaklığı) aralığında rahatlıkla üreyebilir. Düşük sıcaklıklarda üreme yeteneği bakterinin dondurulmuş gıdalarda çoğalmasına imkan verir. Listeriosis, L. monocytogenes ‘in sebep olduğu genel hastalık grubuna verilen isimdir. İnsanlarda menenjit, septisemi, konjonktivit, deri ve mukoza lokasyonları ve kan tablosunda monositoz görülebilir.
Listeria monocytogenes insan ve hayvanlarda değişik enfeksiyonlar meydana getiren, gram pozitif, tekli veya kısa zincir formunda, çomak şeklinde, hareketli (18-26°C’de), sporsuz ve kapsülsüz bir bakteridir. Son derece dayanıklı ve 4°C (buzdolabı sıcaklığı) - 37°C (vücut sıcaklığı) aralığında rahatlıkla üreyebilir. Düşük sıcaklıklarda üreme yeteneği bakterinin dondurulmuş gıdalarda çoğalmasına imkan verir. Listeriosis, L. monocytogenes ‘in sebep olduğu genel hastalık grubuna verilen isimdir. İnsanlarda menenjit, septisemi, konjonktivit, deri ve mukoza lokasyonları ve kan tablosunda monositoz görülebilir.
Bununla birlikte, listeriosis hastalığının asıl öldürücü etkisi, sinir sistemine sıçraması sonucunda yol açtığı menenjit ile gözlenir. L. monocytogenes, taze su, tuzlu su, lağım suyu, toz, toprak, hayvan yemi, gübre ve çürüyen bitkilerden, hayvanların ayaklarından, hayvan kaynaklı pişmemiş gıdalar, taze ve donmuş kümes hayvanları, deniz ürünleri, kırmızı et, et ürünleri, balık, çiğ ve pastörize edilmiş süt, peynir, dondurma, pişmiş sucuk-sosis ve pişmiş tavuk, pişmemiş sebze ve meyveler gibi geniş bir alandan izole edilmektedir. Ayrıca hayvanların ve sağlıklı veya hastalık belirtilerine sahip insanların dışkılarından da izole edilebilmektedir. Kontamine gıdalarda çok az düzeyde bulunan L.monocytogenes, depolanma esnasında soğutma ortamında gelişip çoğalabilmektedir.
Bununla beraber araştırmalarda, normal sağlıklı insanlarda düşük bir düzeyde olduğu, immunsupressif kişilerin, çocukların, yaşlıların, alkoliklerin ve hamile kadınların yüksek risk taşıdığı saptanmıştır.
Aseptik şartlarda alınan numuneler, soğuk zincir korunarak ve bekletmeden analize alınır. Çalışmanın ilk safhasında Listeria türlerinin izolasyonu, ikinci safhasında ise identifikasyonu yapılır. Listeria analizi için standartlarda belirlenen yöntemler gereğince sırasıyla ön zenginleştirme, zenginleştirme, selektif katı besiyerine ekim, kolonilerin incelenmesi, ve identifikasyon için biyokimyasal testler yapılır. L. monocytogenes, diğer Listeria türlerinden farklı olarak katalaz pozitiftir.
Gram ve katalaz pozitif, oksidaz negatif olan, hareket mediumda 25°C’de 7 gün içerisinde şemsiye tarzında üreyen koloniler Listeria şüpheli olarak kabul edilir. Doğrulama için CAMP testi de kullanılabilir. Bu testte şüpheli koloniden öze ile alınan örnek, besiyerinde, S. aureus ile dik açı oluşturacak şekilde çizgi ekim yapılır. Ekimin çaprazlama bölgelerinde görülen hemoliz artışı testin pozitifliğini gösterir. isteria türlerinin kesin identifikasyon için ticari kitler kullanılabilir. Bakterilerin biyokimyasal özelliklerine göre doğrulanması mantığı ile çalışan bu kitler ile tür bazında identifikasyon yapılabilir. Çabuk tanı için floresanlı inceleme, EIA ve PCR yöntemleri kullanılabilir. Bakteriyi yok etmek için tam olarak bir önlem mümkün olmasa da bu bakteriler 75 °C’de öldürüldüğü için, uygun depolanmış, ısıtılmış ve pişirilmiş gıdalar güvendedir. Çapraz kontaminasyon en büyük risktir.
Bu sebeple pişmiş olan gıdaların pişmemiş olanlarla temas haline geçmesini önleyebilmek çapraz kontaminasyonun önüne geçmek için önemlidir. Listeria analizlerinizi yapmak için Toz Besiyeri veya Hazır Besiyeri çeşitlerimizi kullanabilirsiniz. Detaylı bilgi için uzman kadromuz ile sizlere hizmet vermekten mutluluk duyarız. Dilediğiniz zaman bizlere irtibat numaralarımızdan ulaşabilirsiniz.
Escherichia Coli 0157:H7 Aranması
E.coli O157:H7 bakterisinin belirlenmesi için kullanılan analizler klasik ve hızlı yöntemler olarak iki grupta toplanabilir. Klasik yöntemler selektif zenginleştirme ve katı besiyerine ekim aşamalarından oluşur ve var/yok testleri şeklindedir. Türk Gıda Kodeksi verilerine göre gıdalarda E.coli O157:H7 bakterisinin varlığı 25g örnekte araştırılır.
Aseptik şartlarda alınan ve soğuk zincir korunarak laboratuvara getirilen örnekler homojen hale getirilerek, 25g’lık kısmı alınır ve 225 ml selektif sıvı bir besiyerinde 37°C’de 24 saat süreyle zenginleştirme işlemine tabii tutulur. İnkübasyon sonunda selektif ve ayırt edici bir katı besiyerine çift paralelli, sürme ve çizme yöntemleri ile ekim yapılarak, bu besiyerleri de 37°C’de 24 saat inkübasyona bırakılır. Petri florasındaki bazı bakteriler sorbitolü fermente ederlerken bazıları etmez ve petrilerde farklı renklerde koloniler ürer. E.coli O157:H7 şüpheli koloniler sorbitol negatif kolonilerden seçilip doğrulamaya gidilerek belirlenir. Selektif katı besiyerinden elde edilen Sorbitol negatif kolonilerden yapılacak doğrulama biyokimyasal testler yoluyla olabileceği gibi, doğrudan lateks agglutinasyon testi uygulanarak da yapılabilir. Bu yolla bakterinin E. coli O157 olduğu belirlenebilmektedir. Bakterinin E.coli O157:H7 olarak tanımlanabilmesi için H7 antiserumu ile mümkün olmaktadır.
Biyokimyasal doğrulamalarda E.coli O157:H7’nin karakteristik özellikleri
 Hidrojen sülfür negatif
Hidrojen sülfür negatif- Voges Proskauer negatif
- Sorbitol negatif
- Laktoz pozitif
- Glikozdan gaz oluşumu pozitif
- İndol pozitif
- Metil red pozitif
- Hareket pozitif
- Lizin dekarboksilaz (LDC) pozitiftir.
Doğrulamalarda kullanılabilecek diğer bir yöntem lateks agglutinasyon testleri ise iki adet serum içermektedir. Test solüsyonu E.coli O157 antijenine özel tavşan antikorları ile kaplanmış lateks partiküllerinden, kontrol serumu ise pre-immun tavşan globülinlerinden oluşur. Lateks agglutinasyon testinde şüpheli koloni ile karıştırılan kontrol serumunda herhangi bir değişiklik görülmezken, test serumunda oluşan agglutinasyon (kumlanma görüntüsü) E.coli O157’yi doğrular. Klasik yöntemlerin zaman zaman yetersiz gelmesi ve refakatçi floranın maskelemesi sebebiyle yanlış negatifler sıklıkla görülmektedir; bu sebeple yeni ve hızlı analiz yöntemleri ağırlıklı olarak DNA esaslı testler ve immunoenzimatik yöntemler üzerine yoğunlaşmışlardır. İmmunoassay, radioimmunoassay (RIA), fluorescent immunoassay (FIA), enzim immunoassay (EIA), immun peroksidaz testleri gibi testler güvenli ve hızlı sonuçlar verebilmektedir. İmmünolojik belirleme ve identifikasyon lateks agglutinasyon testleri ve ELISA sıklıkla kullanılmaktadır. Bu hassas testlerin sonucunda, antijen-antikor birleşmesi ile, 1 kob/g’dan daha az sayıda E.coli O157:H7 varlığı belirlenebilmektedir. Son zamanlarda E.coli O157:H7 ve toksinleri PCR yöntemi ile de belirlenebilmektedir.
Gıdalarda, hastalık yapan ve asla bulunmaması gereken mikroorganizmalardan biri de koliform bakterilerdir. Koliform bakterilerin en bilineni ve zararlı olan Escherchia coli’ dir. E.coli, çoğunlukla memeli hayvanların bağırsaklarında yaşamaktadır. Bu nedenle gıdalara bulaşmış olması demek ürünün dışkı ile bir şekilde kontamine olması demektir. E.coli, en tehlikeli patojen mikroorganizmalardandır. Vücut ısısında hızlı bir şekilde çoğalır ve ölümcül rahatsızlıklara neden olur. E.coli önemli bir hijyen kriteri kabul edilir. Bir gıda işletmesinde yüzey, personel ve kullanım sularında kontrol edilir. Gıdalarda “Escherchia coli Aranması” için bize ulaşabilirsiniz.
Sülfit İndirgeyen Anaerobik Bakteri Sayımı
 Sülfiti indirgeyen tek Clostridium türü Cl. Perfingens’tir. Cl. Perfingens tanım olarak anaerobik, gram pozitif, spor oluşturan çubuk şeklinde bir bakteri türüdür.
Sülfiti indirgeyen tek Clostridium türü Cl. Perfingens’tir. Cl. Perfingens tanım olarak anaerobik, gram pozitif, spor oluşturan çubuk şeklinde bir bakteri türüdür.
Gıda sanayinde ‘Sülfat indirgeyen Clostridium’ olarak adlandırılır. Cl. Perfingens, birçok karbonhidratı fermente etme yeteneğine sahipken aynı zamanda nitratı indirger ve sütte gazlı fermentasyona neden olur. Perfingens zehirlenmesi, genellikle çok sayıda kişiye yemek hazırlanan, iş yerleri, okullar, hastaneler, yurtlar, hapishaneler gibi yerlerde yetersiz pişirme, yetersiz soğutma veya tekrar ısıtma gibi nedenlerden oluşabilir. Gıda maddelerinde Sülfit indirgeyen anaerobların sayımı genelde bakteri sayısının koloni oluşumu ile sayılamayacak kadar düşük ise En Muhtemel Sayı (EMS) yöntemi ile yapılır. EMS yöntemi ile hazırlanan dilüsyonlardan uygun besiyerlere ekim yapıldıktan sonra üreme sonuçları kontrol edilerek sayı hesaplanır. En yaygın olarak kullanılan besiyer ise TSC Agar besiyeridir. Beklenen sayıya göre dökme veya yayma sayım yöntemi kullanılabilir. Siyah renk oluşumu sülfit indirgeyen Clostridium’ ların varlığını gösterir.
ISO 15213 : Gıda Ve Hayvan Besleme Maddelerinin Mikrobiyolojisi - Anaerobik Koşullar Altında Büyüyen Sülfit Azaltıcı Bakterilerin Sayımı İçin Yatay Yöntem TS EN ISO 7937 Gıda ve Hayvan Yem Maddeleri – Clostridium Perfingens’tir sayımı çin yatay yöntem – Koloni sayım yöntemi Uluslararası akreditasyona sahip laboratuvarlarımız Sülfit İndirgeyen Anaerobik Bakteri Sayımı analizini; gıda, yemlerde gerçekleştirmektedir. Sülfiti indirgeyen tek Clostridium türü Cl. Perfingens’tir. Cl. Perfingens tanım olarak anaerobik, gram pozitif, spor oluşturan çubuk şeklinde bir bakteri türüdür. Gıda sanayinde ‘Sülfat indirgeyen Clostridium’ olarak adlandırılır. Cl. Perfingens, sütte gazlı fermentasyona neden olur ve nitratı indirger. Cl. Perfingens, doğada çok yaygın bulunur. Bu nedenle, gıdalara bulaşmasını önlemek için hijyen ve sanitasyon şartlarının tam anlamıyla sağlanmış olması gerekmektedir. Gıdalarda “Sülfit İndirgeyen Anaerobik Bakteri Sayımı” için bize ulaşabilirsiniz.
Enterococcus & Streptococcus Aranması
Gıdaların tüm üretim, depolama, nakliye gibi aşamalarında hijyen kurallarına uyulmaması ile gıdalarda hem mevcut mikroorganizma yükü hem de kontaminasyon sonucu mikroorganizma yükü artabilir.
Isı ve nem gibi çevresel şartlardan etkilenen gıdalar için bu durum daha hassas olmaktadır.
Mikroorganizma yükünün artması, maddi zararlara neden olacağı gibi gıda zehirlenmelerine neden olarak halkın sağlığını tehdit eder duruma gelmektedir. Gıda zehirlenmelerine neden olan, indikatör mikroorganizmalar gıda sanayinde hijyenik ve kaliteli üretim yapılıp yapılmadığının göstergesi kabul edilir. Enterokok lar, gram pozitif, fakültatif anaerobik, sporsuz ve hareketsiz bakterilerdir. Enterokok lar, sularda, toprakta, çeşitli besin maddelerinde, insan ve hayvanların bağırsaklarında bulunabilirler. Genelde Enterokok lar gıda işlenmesinde kullanılan ısıtma, kurutma, dondurma gibi işlemlere ve çeşitli temizlik işlemlerine karşı dirençlidir. Bu nedenle; ısıl işlem, dondurma gibi işlemlere tabi tutulan gıdalar için koliform bakterilere göre daha iyi bir sanitasyon işlemi gerekmektedir. Isıtma, dondurma, kurutma gibi işlemler görmüş tüketime hazır gıdalar için Enterokok varlığı işlem görmemiş gıdalardan daha önemlidir.
Gıda ürünlerinde, Enterokok lar aranmakta ve alınan sonuca göre üretim, işletme hijyeni, personel hijyeni ve çalışma ortamı hakkında fikir sahibi olabilmekteyiz. Gıda ürünlerinde, mevzuata uygunluk kapsamında yapılan çalışmalarda; “Gıda Güvenliği ve Kalitesinin Denetimi ve Kontrolüne Dair Yönetmelik” esas alınmaktadır. Türkiye’nin birçok yerinde hizmet veren laboratuvarlarımızda TÜRKAK akreditasyonu ile ilgili yasal düzenlemelere ve standartlara uygun bir şekilde gıda güvenliğinin ve kalitesinin sağlanması için gerekli “Mevzuata Uygunluk” çalışmalarını sürdürmektedir.
22C ve 37C ‘de Üreyebilen Mikroorganizmaların Sayımı
 Bakterilerin gelişimine; sıcaklık, oksijen (O2), ortamın asitliği (pH) ve su aktivitesi (aw) etki eder. Bakterilerin çoğalma hızı zaman ve sıcaklık derecesine bağlı olarak değişmektedir. Hastalık yapan bakteriler 5-60oC gibi geniş bir sıcaklık aralığında çoğalır. Bu sıcaklık aralığı tehlikeli sıcaklık aralığı olarak bilinmektedir.
Bakterilerin gelişimine; sıcaklık, oksijen (O2), ortamın asitliği (pH) ve su aktivitesi (aw) etki eder. Bakterilerin çoğalma hızı zaman ve sıcaklık derecesine bağlı olarak değişmektedir. Hastalık yapan bakteriler 5-60oC gibi geniş bir sıcaklık aralığında çoğalır. Bu sıcaklık aralığı tehlikeli sıcaklık aralığı olarak bilinmektedir.
Birçok bakteri orta derece sıcaklığa karşı duyarlı olduğundan özellikle oda sıcaklığı yiyeceklerin saklanmasında en tehlikeli ortamdır. Gıdaları depolama, hazırlama, pişirme, ısıtma ve servisi sırasında tehlikeli sıcaklık aralığında tutmamak gerekir. Ayrıca insan vücudunun sıcaklığı olan 37oC bakterilerin çok hızlı bir şekilde çoğaldığı sıcaklık derecesidir. Özellikle 37-63oC sıcaklık aralığında bakteriler azalarak da olsa çoğalmalarını sürdürmekte ve 63oC sıcaklığın üstünde çoğalmaları durmaktadır. Bakterilerin 37oC’den 5oC’ye doğru düşen sıcaklıklarda çoğalmaları azalarak sürmektedir. Buzdolabının soğutucu bölme sıcaklıklarında (0 ile +4oC) bakteriler yaşamlarını sürdürürler ancak çoğalamazlar. Uygun koşullar sağlandığında gıdaları bozan bakteriler hızlı bir şekilde çoğalır ve sayıları 30 dakikada 2 katı veya üstüne çıkabilir. Bakterilerin çoğalma hızı zaman ve sıcaklık derecesine bağlı olarak değişmektedir.
Hastalık yapan bakteriler 5-60oC gibi geniş bir sıcaklık aralığında çoğalır. Bu sıcaklık aralığı tehlikeli sıcaklık aralığı olarak bilinmektedir. Birçok bakteri orta derece sıcaklığa karşı duyarlı olduğundan özellikle oda sıcaklığı yiyeceklerin saklanmasında en tehlikeli ortamdır. Gıdaları depolama, hazırlama, pişirme, ısıtma ve servisi sırasında tehlikeli sıcaklık aralığında tutmamak gerekir. Ayrıca insan vücudunun sıcaklığı olan 37oC bakterilerin çok hızlı bir şekilde çoğaldığı sıcaklık derecesidir. Özellikle 37-63oC sıcaklık aralığında bakteriler azalarak da olsa çoğalmalarını sürdürmekte ve 63oC sıcaklığın üstünde çoğalmaları durmaktadır. Bakterilerin 37oC’den 5oC’ye doğru düşen sıcaklıklarda çoğalmaları azalarak sürmektedir. Buzdolabının soğutucu bölme sıcaklıklarında (0 ile +4oC) bakteriler yaşamlarını sürdürürler ancak çoğalamazlar.
Uygun koşullar sağlandığında gıdaları bozan bakteriler hızlı bir şekilde çoğalır ve sayıları 30 dakikada 2 katı veya üstüne çıkabilir. Mezofil (ılık seven) Bakteriler: Özellikle insan ve sıcak kanlı hayvanlarda hastalık yapan bakteriler bu gruba dahildir. En iyi çoğaldıkları sıcaklık 20-45°C arasındadır. Ölü materyal üzerinde hayatlarını sürdüren birçok saprofit mezofilik bakteriler en iyi 30°C’de gelişirler. Staphylococcus aureus, Clostridium botulinum ve bazı Salmonella ile Streptococcus türleri bu gruba girer.
Stafilokokal Enterotoksin Aranması
 Stafilokokal enterotoksinler, basit proteinlerin suda çözünebilen bir grubudur. Enterotoksijenik stafilokoklar gıdalarda sindirim sistemi üzerinde etkili olan enterotoksinleri meydana getirirler ve “Stafilokokal Gıda Zehirlenmelerine” neden olurlar. S. aureus enterotoksin üreten stafilokok türleri arasında en önemlisidir. Stafilokoklar, insan sağlığını olumsuz etkileyen bir patojenlerdir.
Stafilokokal enterotoksinler, basit proteinlerin suda çözünebilen bir grubudur. Enterotoksijenik stafilokoklar gıdalarda sindirim sistemi üzerinde etkili olan enterotoksinleri meydana getirirler ve “Stafilokokal Gıda Zehirlenmelerine” neden olurlar. S. aureus enterotoksin üreten stafilokok türleri arasında en önemlisidir. Stafilokoklar, insan sağlığını olumsuz etkileyen bir patojenlerdir.
Genellikle ağız-burun derisi ve mukozasına, el ve ayak derisine, saç ve bıyık gibi kıl diplerine ve kulak yoluna yerleşirler. S. aureus, Vücut direnci düşmesi, vücuttaki bakteri sayısında artış olması veya enterotoksin oluşması durumunda tehlikeli duruma gelir. Stafilokokal enterotoksinler, termostabil karakterde olan pastörizasyon sıcaklıklarında tahrip olmazlar. Özellikle süt ineklerinde S. aureus nedeniyle mastitis hastalığı ortaya çıkar. “Stafilokokal Gıda Zehirlenmesi” gıdanın 100 gramında en az 100 ng enterotoksin bulunması durumunda ortaya çıkar. S. aureus, özellikle gıda endüstrisinde çalışan kişilerin burnunda veya ellerinde bulunabilir. Gıda ürünlerinde, stefilokoklar aranmaktadır ve tespit edilmesi durumunda üretim, işletme hijyeni, personel hijyeni ve çalışma ortamı hakkında fikir sahibi olabilmekteyiz. Gıda ürünlerinde, mevzuata uygunluk kapsamında yapılan çalışmalarda; “Gıda Güvenliği ve Kalitesinin Denetimi ve Kontrolüne Dair Yönetmelik” esas alınmaktadır.
Türkiye’nin birçok yerinde hizmet veren laboratuvarlarımızda TÜRKAK akreditasyonu ile ilgili yasal düzenlemelere ve standartlara uygun bir şekilde gıda güvenliğinin ve kalitesinin sağlanması için gerekli “Mevzuata Uygunluk” çalışmalarını sürdürmektedir. Stafilokokal enterotoksinler, basit proteinlerin suda çözünebilen bir grubudur. Enterotoksijenik stafilokoklar gıdalarda sindirim sistemi üzerinde etkili olan enterotoksinleri meydana getirirler ve “Stafilokokal Gıda Zehirlenmelerine” neden olurlar. S.aureus enterotoksin üreten stafilokok türleri arasında en önemlisidir. S. aureus, özellikle gıda endüstrisinde çalışan kişilerin burnunda veya ellerinde bulunabilir. Gıda ürünlerinde, stefilokoklar aranmaktadır ve tespit edilmesi durumunda üretim, işletme hijyeni, personel hijyeni ve çalışma ortamı hakkında fikir sahibi olabilmekteyiz. Gıdalarda “Stafilokokal Enterotoksin Aranması” için bize ulaşabilirsiniz.
ISO belgesi fiyatı ve teklif
Ön teklif almak için butona tıklayarak teklif sayfamıza geçebilir, talebinizi orada iletebilirsiniz; ekibimiz değerlendirdikten sonra size dönüş yapar.